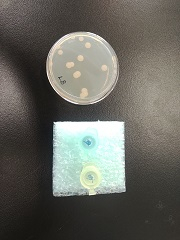
スターターセット
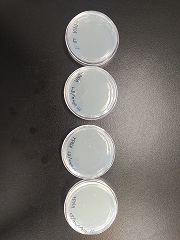
大腸菌
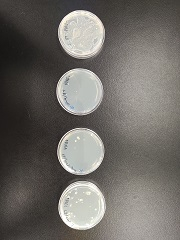
自然光

ニュース
2023/11/09 お知らせ
遺伝子組み換え実験をしました=生物=
生物 (3年次)
2年次に「生物基礎」を履修した生徒を対象としています。
生物的な事物・現象についての観察・実験や課題研究などを行い、自然に対する関心や探究心を高め、生物的に探究する能力と態度を育てるとともに基本的な概念や原理・法則を理解し、科学的な自然観を養うことを目標としています。
今回の授業では大腸菌にオワンクラゲの蛍光緑色タンパク質(GFP)が組み込まれたプラスミドを使用して、遺伝子組換え実験を行いました。
実験が成功した班は、保護メガネをして紫外線ランプを当てると蛍光緑色に光りました。とても綺麗で、感動します。
実験が成功しなかった班は、いろいろな原因を考えるのも勉強だと思います。
実験を行うために、校長先生に申請して許可をもらい、最後は全てのプレートを滅菌処理して、報告書を提出しました。
|
 |
 |
|
 |
|
 |
 |
